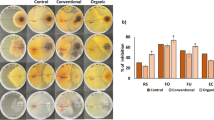

Abstract
Background
Fungicides are an effective tool for protecting crops and maintaining a steady food supply. However, as pathogens continue to evolve, it is crucial to prolong the effectiveness of fungicides by delaying resistance development. A key strategy to achieving this is to combine or rotate fungicides with different modes of action. As fungicides lack specificity, they inevitably affect both pathogenic and non-pathogenic fungi when surrounding environments are unintentionally contaminated. Our study aims to investigate the effects of recommended application methods to prevent resistance development, specifically repeated-single fungicide, simultaneous mixture, and sequential applications on non-target soil fungi, and the subsequent impacts on important soil processes. We used fungicides with different modes of action on soil microcosms inoculated with fungi at varying levels of diversity (3, 5, and 8 species) isolated from a protected grassland.
Results
We found that repeated treatments of individual isopyrazam and prothioconazole differentially inhibited fungal activity. Although mixture applications are considered more protectant against crop pathogen resistance than repeated application, our study revealed stronger negative effects of simultaneous application on saprobic fungi and consequently on soil processes. However, contrary to expectations, higher fungal diversity did not translate to improved soil function under these conditions.
Conclusions
The simultaneous application of fungicides with different modes of action (MoA) has more pronounced non-target effects on soil compared to the individual or sequential application of fungicides. These non-target effects extend beyond the intended control of pathogenic fungi, impacting saprobic and beneficial soil microbes and the critical processes they drive. When fungicides are applied concurrently, microbial activities in the soil are significantly altered, even in soils with high microbial diversity. Our study emphasizes the importance of carefully considering the unintended consequences of fungicide use in agriculture. As we strive for a secure food supply, it is crucial to investigate the broader environmental impacts of these chemical interventions, including their effects on non-pathogenic fungi and overall soil health.
Similar content being viewed by others
Explore related subjects
Discover the latest articles, news and stories from top researchers in related subjects.Avoid common mistakes on your manuscript.
Introduction
To ensure a steady global food supply, fungicide use is recognized as an indispensable measure against crop fungal infestation. In Europe, pesticide sales in 2022 totaled 322 million kilograms, marking a 10% decrease from 2021. Fungicides and bactericides were the most sold chemicals, accounting for 43% of the total sales [1]. Pesticides undergo strict regulation processes to ensure effectiveness and minimize impacts on human health, animal health, and the environment. Registration procedure scrutinizes pesticide ingredients, the crop it is intended to be used, the amount and frequency of application as well as storage and disposal [2, 3]. Although this intervention is intended to protect crops from pathogens, the massive and indiscriminate use of fungicides has resulted in numerous environmental and health concerns [4, 5]. For example, improper use and application practices have exposed not only the farmers to toxic ingredients but also individuals who are not directly involved in handling these agricultural products [6, 7]. Environmental contamination is also widespread as the prevalence of fungicides both in surface waters and in soil implies chronic exposure of aquatic biota and terrestrial organisms to these compounds [5, 8,9,10,11]. Animal exposure through inhalation, direct deposition on skin, and consumption of contaminated products produce acute and chronic effects [12,13,14]. Surprisingly, fungicides were also reported to even increase infection and mortality of a tree frog species by an amphibian fungal pathogen [15]. In plants, non-target effects of pesticide application include metabolic disorders, hampered growth and development and oxidative stress, among others [16, 17]. Soil fungi are important in litter decomposition and soil aggregate formation [18,19,20]. Additionally, arbuscular mycorrhizal fungi (AMF) play crucial roles in maintaining soil fertility in agroecosystems, improving plant tolerance to stress and resistance against pathogens [21,22,23]. As fungicides are mostly not species-specific, they may also inhibit these beneficial soil fungi alongside fungal pathogens. Consequently, important soil processes where fungi play important roles may be altered, resulting in poor soil health and low plant diversity and productivity [24].
Unsurprisingly, pesticides are widely distributed in European agricultural topsoil [8]. Among these are broad-spectrum fungicides (with maximum content of residues detected), such as boscalid (0.41 mg kg−1), azoxystrobin (0.25 mg kg−1), epoxiconazole (0.16 mg kg−1), tebuconazole (0.19 mg kg−1), and prothioconazole (0.14 mg kg−1) [8]. But their presence extends beyond conventional farms. Organic farms and extensively managed grassland sites, where pesticides, fertilizers, and manure are not applied, are also subject to the unintentional exposure and distribution of pesticides from surrounding areas [10, 11]. Hence, the ill effects of these chemicals on non-target organisms and areas might be exacerbated by highly persistent and toxic compounds. Despite these, fungicides remain an integral part of safeguarding food supply. Hence, efforts are necessary to ensure the efficiency of these compounds and prevent the development of antimicrobial resistance. As part of the resistance management program, the Fungicide Resistance Action Committee (FRAC) recommends combining fungicides with different modes of action (MoA). Fungicides act against pathogenic fungi in different ways or MoA, such as by inhibiting respiration, nucleic acid metabolism, and protein synthesis, destroying membrane integrity, and inhibiting enzyme activity important for membrane synthesis [25]. Repeated application of a single MoA favors resistance development; hence, two or more fungicides with different MoA are ideally applied either simultaneously in tank mixes or sequentially [26]. Sequential application involves the application of two or three fungicides in series within the cropping season. Combining fungicides broadens the spectrum of disease control by the additive or synergistic interactions of the component fungicides [26,27,28]. Results of available studies have been inconclusive; however, most of them reported that simultaneous application provides better protection than the sequential or alternating application [29, 30]. The success with these two strategies greatly depends on the choice of the mixed compounds, their dose, relative efficacy, and the persistence of the fungicides in the combination [30, 31]. As these two application methods are targeted against resistance development in pathogenic fungi, their indirect side effects on non-target soil microbiota, particularly on fungi, are not given much attention. Additionally, broadening the spectrum of disease control inadvertently increases the risk to beneficial soil fungi once these compounds reach the soil [32, 33].
In this study, we evaluate and compare the effects on soil processes of the FRAC-recommended fungicide application strategies aimed against resistance development. We tested two broad-spectrum fungicides with different modes of action, specifically a demethylation inhibitor (DMI) which inhibits sterol biosynthesis, and a succinate dehydrogenase inhibitor (SDHI) which disrupts cellular respiration. The DMI fungicide prothioconazole, commonly used to control cereal pathogens, has been available for over 20 years, whereas the SDHI fungicide isopyrazam, approved by the European Union in 2012, is a relatively newer product. These fungicides were applied individually and in combination using simultaneous and sequential application methods in soil microcosms inoculated with soil fungi. The fungal species used had no known resistance against these fungicides and were isolated from a protected grassland with no history of deliberate fungicide exposure. Given the crucial role of fungi in various soil processes, such as nutrient cycling and soil structure formation, fungal inocula were prepared to create communities with varying compositions and levels of diversity. This approach aimed to determine the impact of fungal diversity on maintaining a stable environment under fungicide stress. Fungal species included in our study have varying sensitivities to the test fungicides [34]. Moreover, Lehmann et al. [35] reported the varying aggregation capabilities of these fungi, from poor to good aggregate formers. Fungi contribute to soil aggregation by forming hyphal networks that enmesh soil aggregates and by exuding biopolymers that act as natural adhesives [19]. Given that phylogenetic relationships significantly influence fungal responses to fungicides and their capacity for aggregation, we selected species from three distinct phyla, namely, Ascomycota, Basidiomycota, and Mucoromycota. We investigated the effects of fungicide treatments to known proxies of soil health including soil respiration, soil aggregation, fluorescein diacetate (FDA) hydrolysis, and enzyme activities involved in nutrient cycling using soil microcosms. Microcosms were prepared from grassland soil with no history of fungicide application to eliminate confounding effects of background fungicide contamination. Here, we hypothesized that the fungicides would differ in their individual effects by virtue of their modes of action. Additionally, the fungicide mixture will negatively affect the soil parameters more strongly than the individual components potentially due to complementary or additive interaction. As ecosystem process rates are often well correlated with species diversity [36], we also hypothesized that the negative effects of fungicides are weaker in soils with higher fungal diversity. Our findings aim to provide insights into how fungicide application strategies aimed at delaying resistance to fungicide might impact soil processes, informing best practices for sustainable agriculture.
Methodology
Selection of test organisms Eight fungal isolates were chosen from a set of filamentous, saprobic soil fungi originally isolated from a natural grassland in Mallnow Lebus, Brandenburg in Germany [37]. These cultures have been extensively studied in the lab to characterize a wide array of traits including aggregation potential, enzymatic capabilities, spore production, and fungicide sensitivities among others [34, 35, 38,39,40]. Sensitivity to the fungicides prothioconazole and isopyrazam has been tested in a previous study [34]. Fungal cultures were chosen based on the following criteria: (1) taxonomic affiliation covering three phyla; (2) sensitivity to the fungicides; and (3) soil aggregate formation ability. These important traits may influence their responses to fungicide application and in turn affect soil properties and functions. Species names with the unique identifiers (RilligLab Coreset, RLCS) used in this study and their relevant traits are included in Table S1. Eight species representing three major fungal phyla were used namely: Ascomycota (Fusarium sp., Chaetomium angustispirale, Fusarium gibbosum, Gliomastix sp.); Basidiomycota (Pleurotus sp., Clitopilus sp.); and Mucoromycota (Mucor fragilis, Umbelopsis isabellina). Spores were harvested from 14-day-old fungal cultures grown in Potato Dextrose Agar and quantified microscopically [38]. Suspensions of the individual isolates were brought to 5 × 104 spores concentration using phosphate-buffered saline (PBS) solution. From these, fungal inocula with different levels of diversity (F3, F5, and F8) were prepared by mixing 50 μL from each isolate. Random draws from a pool of 8 isolates were done corresponding to the diversity level such that F3 had 3 draws, F5 had 5 draws and F8 had 8 draws. Each diversity level had 6 replicates and for each replicate, sampling was done without replacement (see Table S2 for combinations). This design focuses on the diversity level of fungi in the inoculum rather than on the identity and composition. Inocula were re-adjusted to a final working concentration of 5 × 104 spores per ml with PBS solution using a dilution method, so that each sample received the same overall load of spores. To confirm viability, aliquots of the spore suspensions were inoculated on freshly prepared Potato Dextrose Agar.
Preparation of fungicides The physicochemical properties, chemical structures, and recommended field rate of prothioconazole (Sigma-Aldrich, ≥ 98% purity) and isopyrazam (Sigma-Aldrich, ≥ 98% purity) are detailed in Table S3. These fungicides are used to eliminate fungal pathogens of cereals and other crops such as vegetables due to their broad-spectrum activity. Additionally, their effects on the growth rates of RLCS coreset fungi are known [34]. The stock solutions were prepared by initially dissolving the compounds in DMSO and subsequently adding deionized water. From these, final working concentrations of 2 mg L−1 were prepared. This application concentration is known to reduce fungal growth but is not lethal [34].
Soil microcosm preparation Soil microcosms were prepared from fresh soil (Albic Luvisol, 73.6% sand, 18.8% silt, and 7.6% clay) collected from a grassland field site of Freie Universität Berlin, Germany. To remove large debris and obtain a homogenized sample, soil was sieved using a 2 mm metal sieve. Each 25 g soil was thoroughly mixed with 5 g sand using metal spatula to partially compensate for anticipated nutrient release during sterilization [41]. These were then carefully transferred to 50 mL polypropylene conical tubes (Fisherbrand™, Fisher Scientific), covered with caps modified with rubber stopper to facilitate respiration measurements during the study. The microcosms were sterilized (121 °C, 20 min) twice with at least 24 h in between to eliminate viable microbial propagules from the soil. Sterile deionized water amended with glucose (4 mg g−1 soil) [42] was added to the tubes to achieve 60% final water holding capacity allowing the water to passively spread throughout the microcosm. Glucose is used to stimulate the growth of the fungi without interfering with soil aggregate formation [42,43,44]. Control groups received the same amount of water and glucose addition. Each soil microcosm received 1 ml of the spore suspension. Soil microcosms including the control tubes were mixed manually using a sterile metal spatula.
Experimental design
Inoculated tubes were pre-incubated for 7 days without fungicide treatment to allow spore germination and acclimation. Baseline soil respiration was measured to verify growth after this period. Fungicide treatments were then applied (1) repeatedly as a single compound, (2) simultaneously as a mixed solution, or (3) sequentially (alternating application of two fungicides) (Table S4). Sequential applications were done in two ways (SeqPI and SeqIP). In SeqPI, prothioconazole was first added on day 1 of treatment, followed by isopyrazam on the next day and so on until the 7th day. In SeqIP, the sequence was reversed so that the isopyrazam is added first. Fungicide treatment was done in a dose-day approach by gradually adding 0.1 ml of fungicide solution every 24 h for 7 days (Figure S1). This simulates repeated contamination and accumulation of sub-lethal concentrations in soil. Independent of application type, each microcosm received 0.2 µg of total fungicides per day. At the end of the experiment, a total of 0.046 mg fungicide kg−1 dry soil is added. This concentration is comparable to the detected fungicide residue of prothioconazole (median = 0.04 mg kg−1) and overall fungicide (maximum range = 0.01–0.41 mg kg−1) in agricultural soil [8]. For the control groups, 0.1 ml of sterile distilled water without fungicide was added daily. Soil mixing after fungicide addition was skipped to simulate natural conditions where concentration gradients develop in soil. In total, 108 experimental units were prepared (5 fungicide treatments × 3 inoculum diversity levels × 6 replicates = 90) including untreated soil samples (3 inoculum diversity levels × 6 replicates = 18). Tubes were loosely capped and sealed with parafilm to allow gas exchange and minimize contamination and placed in a randomized manner inside an incubator set at 25 °C for 7 days.
Measurement of fungal activities and soil properties
Microbial activities Soil respiration was measured after 7 days of pre-incubation before introducing the fungicide treatments (baseline respiration) and on the last experimental day (7 days after treatment). Prior to measurements, tubes were flushed with CO2-free air for 10 min to eliminate background CO2 and kept in an incubator for 2 h. Approximately 1 ml of extracted gas samples was injected into an infrared gas analyzer (LI-6400XT, LI-COR Inc., Bad Homburg, Germany) and reported as CO2 concentration (ppm h−1 g−1 soil). Enzyme activities were measured using high-throughput microplate assays and quantified using a microplate reader (Bio-Rad Lab., Hercules, USA). Fluorescein diacetate (FDA) hydrolytic activity involves a wide spectrum of enzymes, such as lipase, protease, and esterase, and correlates well with the amount of fungal biomass [45, 46]. Hence, it was used to measure total fungal activity in soil [47]. Additionally, to assess the ability of the added fungal community to acquire nutrients, activities of β-glucosidase (cellobiose degradation), phosphatase (organic phosphorus mineralization), and N-acetyl-β-D-glucosaminidase (nitrogen mineralization) were measured.
Water-stable aggregates Using a wet sieving apparatus (Eijkelkamp, Giesbeek, Netherlands), water-stable aggregates (> 250 µm) were determined following an established method [44, 48]. More detailed procedures are included in the Supplementary Information.
Statistical analysis
The effects of the different fungicide application strategies on microbial activities and soil functions were analyzed using linear models and multiple comparisons tests. Model residuals were checked to validate assumptions of normality and homogeneity of variances. Generalized linear models (glm) followed by a post hoc Tukey test in the R package “multcomp” were used to make comparisons among treatments. Additionally, perMANOVA (permutational multivariate analysis of variance) was used to determine the main effects and interactions of fungicide treatments and inoculum diversity level on the measured parameters using the R package “vegan”. Treatment effect sizes were calculated using the R package “dabestr” [49]. This approach included the calculation of the 95% confidence interval (CI) of unpaired mean differences (treatment minus control). To evaluate the correlation among the tested parameters under the fungicide and diversity treatments, principal component analysis (PCA) was performed. All variables were scaled to mean = 0 and standard deviation = 1 before PCA. The significance of the principal components and corresponding contributions of each variable was evaluated using a permutation-based test of the function PCAtest () [50]. Data included were obtained from measured proxies for soil microbial activities, such as soil respiration and FDA hydrolysis activity. In addition, data on measured soil processes, such as water-stable aggregation and enzyme activities associated with nutrient cycling (i.e., β-glucosidase, phosphatase, N-acetyl-β-D-glucosaminidase activities), were also included. All plots were generated with the package “ggplot2” [51]. All statistical analyses and data visualization were performed in R version 4.2.1[52].
Results
Negative effects on microbial activities (soil respiration and FDA hydrolysis)
Growth on Potato Dextrose Agar (PDA) confirmed viability of the fungal spores used for inoculation. Likewise, initial respiration measured before the fungicide addition confirmed growth of inoculated fungi in the soil microcosms (Figure S2). After the treatments, established proxies for soil health were measured including parameters for microbial activities (soil respiration and FDA hydrolysis activity) and soil functions (enzyme activities and water-stable aggregation). Soil respiration, FDA hydrolysis, and soil aggregation were the highest in F8-inoculated untreated soil samples (Control F8). Conversely, F3-inoculated soil (Control F3) had the lowest fungal activities among the control groups. The enzyme activities, however, displayed a variable pattern across the different inoculum diversity levels (Figure S3).
Fungicide treatments, regardless of the application technique, significantly reduced soil respiration in the F8 inoculum, with the most pronounced negative effect observed under simultaneous treatment (SM) (Fig. 1). Similarly, in the F3 and F5 inoculum, a strong negative effect was evident under the SM treatment, though this effect was not observed in other fungicide applications. Effects of repeated prothioconazole application (RP) on soil respiration were comparable to that of repeated isopyrazam (RI) treatments (Table S5). Likewise, effects of sequential applications (SeqPI and SeqIP) did not differ significantly from each other. Among the different diversity levels, effect sizes (treatment minus control) were most evident in the F8-inoculated soil (Fig. 1, Table S5). FDA hydrolysis, another known indicator of microbial activity, was significantly inhibited when fungicides are applied as mixtures but not as individual fungicides (Fig. 2). However, in the F8 inoculum, repeated isopyrazam (RI) application had significantly lower FDA hydrolysis than the prothioconazole counterpart (RP). On the other hand, effects of mixture treatments (SM, SeqPI and SeqIP) were not distinct in all diversity levels.
Effects of fungicide treatments on soil respiration. Upper panel shows raw data (gray) presented as swarm plots with the corresponding mean and standard deviation (n = 6, blue). The multi-group estimation plot (lower panel) displays the unpaired mean difference between each treatment and the shared control. Soil samples with different levels of fungal diversity (F3, F5, F8) and without added fungicides were used as control groups separately. Density plot shows data distribution including the mean (dot) and 95% confidence interval (vertical line), black are significant effects and gray are neutral effects. RP repeated prothioconazole, RI repeated isopyrazam, SM simultaneous mixture, SeqPI sequential prothioconazole-isopyrazam, SeqIP sequential isopyrazam-prothioconazole. Model outcomes are presented in Table S5
Effects of fungicide treatments on FDA hydrolysis. Upper panel shows raw data (gray) presented as swarm plots with the corresponding mean and standard deviation (n = 6, blue). The multi-group estimation plot (lower panel) displays the unpaired mean difference between each treatment and the shared control. Soil samples with different levels of fungal diversity (F3, F5, F8) and without added fungicides were used as control groups separately. Density plot shows data distribution including the mean (dot) and 95% confidence interval (vertical line), black are significant effects and gray are neutral effects. RP repeated prothioconazole, RI repeated isopyrazam, SM simultaneous mixture, SeqPI sequential prothioconazole-isopyrazam, SeqIP sequential isopyrazam-prothioconazole. Model outcomes are presented in Table S5
Limited effects on soil functions (soil enzymes and water-stable aggregation)
Fungicide treatments slightly increased β-glucosidase (Figure S3A) and phosphatase activity (Figure S3B). Significantly higher activity of these two enzymes was noted on SM-treated soil inoculated with F3 and F5, but not F8. However, the overall effect of fungicides to β-glucosidase, phosphatase and N-acetyl-β-D-glucosaminidase (Figure S3C) activities remained neutral. For all three enzymes, there was no difference in effect between the repeated treatments (RP and RI). Likewise, sequential treatments (SeqPI and SeqIP) were also comparable. Like enzyme activities, there were no remarkable differences observed in the water-stable soil aggregation of fungicide-treated soil and the control groups for both F3- and F5-inoculated soil samples (Figure S4). However, repeated prothioconazole application reduced soil aggregation significantly in the F8-inoculated soil.
Correlation among soil parameters and samples
The general relationships among the different soil parameters tested and the individual samples were evaluated using principal component analysis (Fig. 3). We found that 30.7% and 21.4% of the variability in soil parameters tested were accounted for in the first and second PC axes, respectively. Variables related to fungal activity loaded on the first axis, while enzyme activities loaded on the second axis, differentiating fungicide treatments from control. Soil respiration was positively correlated with FDA hydrolysis. Enzyme activities pertinent to nutrient cycling were also well correlated. Control groups and samples treated with repeated application of single fungicides were mostly clustered in the quadrant where microbial activity is high, while the simultaneous treatment (SM) clustered in the opposite quadrant. A clear separation was also evident between the low diversity (F3) and the high diversity (F8) as well as the control groups. Moreover, perMANOVA analyses confirmed that measured soil parameters are affected by fungicide treatments (p-value = 0.001) and inoculum diversity level (p value = 0.010). Likewise, the interaction effects of these two factors significantly contributed to the observed variation in effect sizes (p value = 0.015), suggesting that the effects of fungicide treatments are highly influenced by the fungal diversity in the soil.
Principal component analysis (PCA) projecting the correlation between the different soil parameters tested and the soil samples inoculated with different levels of fungal diversity under the different fungicide application strategies. Samples are distributed in the two-dimensional space represented by principal component axes 1 and 2 explaining 30.7 and 21.4% of variance, respectively. The soil parameters include soil respiration, FDA hydrolysis, water-stable aggregates (WSA), β-glucosidase, phosphatase and N-acetyl-β-d-glucosaminidase (NAGase). Arrows indicate direction and weight of variables. Fungicide treatments are denoted by different shapes with concentration ellipses. Colors indicate data distribution by fungal diversity level (F3, F5 and F8). RP:Repeated prothioconazole, RI:Repeated isopyrazam, SM:Simultaneous mixture, SeqPI:Sequential prothioconazole-isopyrazam, SeqIP:Sequential isopyrazam-prothioconazole
Discussion
Sub-lethal concentrations of prothioconazole and isopyrazam resulted in an overall reduction in soil respiration and FDA hydrolysis indicating reduction in fungal biomass and microbial activities [45, 47, 53,54,55]. Soil samples treated with F8 exhibited the most substantial deviation from their corresponding control group (Control F8) compared to those with lower diversity (F3 and F5). This significant treatment effect is influenced by the higher respiration rates in the F8-inoculated untreated soil compared to the F3- and F5-inoculated soils, i.e., fungicide additions reduced the activity of diverse soil to an activity level of less diverse soils. Despite the difference in modes of action, repeated application of the individual fungicides had comparable effects on soil respiration. However, the effects of these individual fungicide applications on FDA hydrolysis varied significantly, particularly in the F8-inoculated soil. The lower FDA hydrolysis in soil treated repeatedly with isopyrazam can be attributed to the ability of the fungicide to inhibit succinate dehydrogenase (SDHI), a functional enzyme in fungal respiration [56]. Isopyrazam, a protective fungicide, also prevents spore germination, potentially resulting in lower fungal biomass [57,58,59]. In contrast, prothioconazole, a demethylation inhibitor (DMI) fungicide, inhibits ergosterol synthesis required in the formation of cell membranes [60]. Unlike isopyrazam, this fungicide allows spore germination, but fungal growth stops once ergosterol from the spore membrane is depleted [61,62,63]. Our findings aligned with previous reports on the inhibitory effects of SDHI and DMI fungicides on soil respiration [64, 65] and FDA hydrolysis [66]. Tebuconazole, a DMI fungicide, for example, was also found to inhibit substrate-induced respiration after 7 days of incubation in a concentration-dependent manner [64]. Similar concentration-dependent inhibition of soil respiration by boscalid, an SDHI fungicide, was observed by Xiong et al. [65]. However, they reported that at the highest concentration tested (200 mg kg−1), soil respiration was not distinct from the control group. This was attributed to lower degradation potential at higher concentrations. While persistent fungicides may be beneficial in controlling pathogens, they could be more detrimental to non-target organisms, such as soil-borne fungi. Prothioconazole degrades rapidly in soil with half-lives of 5.8 days [67]. However, its main degradation product, prothioconazole-desthio is found to be more persistent in environmental matrices [67, 68]. In another study involving yeast, Parker et al. [69] attributed the antifungal activity of prothioconazole, specifically in the inhibition of ergosterol biosynthesis, to prothioconazole-desthio. Isopyrazam, on the other hand, is reported to have medium to high persistence in soil, while its metabolites have low to very high persistence [70].
Prothioconazole and isopyrazam were also evaluated as a mixture, either simultaneously in a solution or by sequentially adding one fungicide after the other. Our findings supported our second hypothesis that mixture treatments, particularly simultaneous (SM) fungicide application, had the strongest negative effects on soil microbial activities. Additionally, the reduction in FDA hydrolysis under sequential (SeqPI and SeqIP) treatments was significantly different from the individual treatments. Prothioconazole and isopyrazam are broad-spectrum fungicides that inhibit fungal growth via different modes of action. When applied as a mixture, fungicides act in a complementary manner with expected combined toxicity to be higher than their respective components [27, 71]. While these strategies are targeted at delaying pathogen resistance [26], fungicides reaching the soil during field application are inevitable, resulting in unintentional exposure of soil microbes to the toxic effects of fungicides. Our results showed that even short-term exposure to sub-lethal doses of fungicide mixtures affects soil microbial activities. Accumulation via prolonged or continuous application may result in more drastic changes. In another study, Wang et al. [72] reported that low doses of tebuconazole and carbendazim, applied individually and in combination, had no negative effects on respiration but higher doses produced a more pronounced inhibition. This is because fungicides at higher concentrations have a slower biodegradation rate particularly when they are applied in combination [64, 72].
Fungicide treatments had neutral to slightly positive effects on soil enzymes essential for nutrient cycling, namely, β-glucosidase, phosphatase and N-acetyl-β-D-glucosaminidase activities. Stimulation of β-glucosidase and phosphatase activity in soil treated with fungicide is potentially due to the ability of the innately more tolerant fungal species to utilize low concentrations of fungicides as carbon substrates [73]. This result was similar to the findings of Xiong et al. [65], who reported that short-term exposure to boscalid, an SDHI fungicide, had stimulatory effects on β-glucosidase activity. Another DMI fungicides, tebuconazole (single and in mixture with carbendazim) were reported to have a neutral to stimulatory effect on the β-glucosidase activity at low concentrations [72, 74]. In nature, β-glucosidase is essential in carbon acquisition. Agroecosystems, for example, are abundant in cellulose, the main polymer in plant cell walls [75]. Cellulose is converted to cellobiose, and with the aid of β-glucosidase cellobiose is further converted to glucose. This is then utilized by several soil microbes as energy source for growth and various activities [76]. Previous reports showed that large doses and longer incubation had negative effects on β-glucosidase [64, 65, 77]. Therefore, accumulation and continuous exposure to fungicides and their metabolites may potentially result in decreased, rather than enhanced β-glucosidase activity, potentially due to the elimination of relevant soil fungi. Like β-glucosidase, phosphatase is also important for nutrient acquisition. This essential enzyme supports the phosphorus cycle in soil by hydrolyzing esters and anhydrides of phosphoric acid into orthophosphate [78], which is the form taken up by plants [79]. Repeated prothioconazole (RP) application and simultaneous (SM) application of prothioconazole and isopyrazam stimulate phosphatase activity. Previous reports attributed the increase in phosphatase activity to the fungicide being a substrate for tolerant microbes [74, 80,81,82]. On the contrary, the toxicity of fungicides may also be exhibited as reduced phosphatase activity under different application regimes. Reduction varied depending on concentration and exposure time for solo one-time fungicide application [72, 73, 83,84,85], solo repeated application [86], as well as mixture application [72, 83, 87]. Finally, N-acetyl-β-d-glucosaminidase (NAGase) is involved in N and C cycling in soil [88]. In nature, the enzyme is also involved in chitin degradation, the second most abundant polysaccharide after cellulose [89]. In the current study, the fungicides did not produce a significant change in NAGase activity. Riah-Anglet et al. [90] reported that as high as 1000×, the recommended field rate of epiconazole did not affect NAGase activity. This was attributed to the potential adsorption of some free enzymes to organic matters in soil that may have stabilized the activity of the enzyme despite fungicide treatment [90]. Additionally, as the enzyme is carried by a large group of organisms including fungi, compensation among functionally similar species may also play a role [91,92,93].
Short-term fungicide treatments had limited effects on water-stable aggregates. However, the repeated application of prothioconazole significantly reduced soil aggregation in the F8-inoculated soil compared to its corresponding control group. Additionally, the mixture of the two fungicides added sequentially reduced soil aggregation in F5-inoculated soil. Ergosterol synthesis inhibitors like prothioconazole can alter fungal cell membrane morphology and functions and consequently affect hyphal production and network formation [94, 95]. This resulted in substantially lower soil aggregation. Mixing fungicides with different mechanisms of inhibiting fungal growth may have led to reduced biomass particularly to soil with lower fungal diversity. With higher diversity, more tolerant fungal species may have utilized low doses of fungicide and dead cells as substrate to support growth. Consequently, surviving fungi may have compensated for the deaths or inhibition of more sensitive species. This supports previous findings highlighting the positive contribution of filamentous fungi on soil aggregate formation [19, 35, 96]. Fungal hyphal networks, together with adhesive exudates (e.g., exopolysaccharides, glycoprotein mucilages) excreted by fungal hyphae can bind soil particles together enhancing aggregate formation [20, 97].
The strong negative effect of simultaneous fungicide addition on non-target soil fungi resulting in lower microbial activity was clearly illustrated in the PCA plot. Conversely, samples treated with single fungicides had comparable effects with the control groups, clustering in areas indicating higher fungal activity as evidenced by FDA hydrolysis and soil respiration. Our results showed an inverse relationship between soil enzyme activities and fungal activities (i.e., soil respiration and FDA hydrolysis). This suggests that despite the inhibitory effects of fungicides on fungal respiration and biomass production, more tolerant isolates with the relevant functional capabilities may have compensated for the death or inhibition of the sensitive species. Isolates varied widely in their individual responses to both fungicides [34], with some isolates being tolerant to one fungicide and sensitive to another. Such innate tolerance of the individual isolates to the fungicides is an important factor as more tolerant species may offset the loss or inhibition of the sensitive ones, safeguarding the process. This supports the findings of Baudy et al. [98], that community composition of aquatic fungi and not the function was altered upon exposure to environmentally relevant concentrations of fungicides. Also in this paper, they reported that interaction among surviving species have changed from complementarity to competition [98]. Finally, the distinct difference in treatment effects observed between low diversity (F3) and high diversity (F8) soils demonstrated that fungal diversity levels significantly influence the response to fungicide treatments. One limitation of this experiment is that, under field conditions, soil contains a diverse range of microbes, not just fungi, which contribute to the degradation of active substances and influence overall soil properties and chemistry. As a result, biodegradation processes could either diminish or amplify the toxicity of the fungicide, thereby affecting soil fungi in various ways. Additionally, the fungi used in this experiment were selected based on their sensitivity to fungicides. Although the community members were chosen randomly, natural soil fungi can exhibit a broad spectrum of sensitivities. As this current study involved fungi that co-existed in a grassland site with no known history of deliberate fungicide application, other agroecosystems may differ in response, particularly those consistently exposed to fungicides. In agricultural fields, for example, where sensitivity gradients may develop due to repeated or regular fungicide treatment, eventual changes in community composition may occur allowing more tolerant and resistant species to dominate. This may result in altered soil multifunctionality, perhaps to an even greater extent than what was observed in the grassland soil used in this study [66, 99,100,101].
Conclusion
Our study presents the impacts of fungicide application strategies aimed at delaying fungicide resistance on non-target soil fungi and soil processes. Fungi isolated from a protected grassland site and added to soil microcosms at increasing diversity levels were exposed to two fungicides with different modes of action. Our findings reveal that simultaneous application of the fungicides had stronger negative effects on soil compared to repeated application of individual fungicide and sequential application. Initial exposure of grassland soil fungi to concurrent fungicide stress limits their ability to maintain soil processes even in high diversity soil. As the global population continues to grow steadily, cultivated farmlands are also rapidly expanding, leading to unintentional exposure of the surrounding environment and their beneficial soil fungi to the toxic effects of fungicides. We recommend further studies taking into account fungal attributes and functional diversity in investigating fungicide effects on soil processes.
Availability of data and materials
The dataset generated and analyzed during the current study is available at https://doi.org/https://doi.org/10.6084/m9.figshare.26037910.
References
Sales of pesticides in the EU—Products Eurostat News—Eurostat. https://ec.europa.eu/eurostat/web/products-eurostat-news/-/ddn-20200603-1. Accessed 5 Mar 2022
European Food Safety Authority (2021) Pesticide evaluations: overview and procedure. Efsa 1–2
The Environmental Protection Agency (2024) About pesticide registration—pesticide registration process
Oluwole O, Cheke RA (2009) Health and environmental impacts of pesticide use practices: a case study of farmers in Ekiti State, Nigeria. Int J Agric Sustain 7:153–163. https://doi.org/10.3763/ijas.2009.0431
Zubrod JP, Bundschuh M, Arts G, Brühl CA, Imfeld G, Knäbel A, Payraudeau S, Rasmussen JJ, Rohr J, Scharmüller A, Smalling K, Stehle S, Schulz R, Schäfer RB (2019) Fungicides: an overlooked pesticide class? Environ Sci Technol 53:3347–3365. https://doi.org/10.1021/acs.est.8b04392
Damalas CA, Koutroubas SD (2016) Farmers’ exposure to pesticides: toxicity types and ways of prevention. Toxics 4:1–10. https://doi.org/10.3390/toxics4010001
Kim KH, Kabir E, Jahan SA (2017) Exposure to pesticides and the associated human health effects. Sci Total Environ 575:525–535. https://doi.org/10.1016/j.scitotenv.2016.09.009
Silva V, Mol HGJ, Zomer P, Tienstra M, Ritsema CJ, Geissen V (2019) Pesticide residues in European agricultural soils—a hidden reality unfolded. Sci Total Environ 653:1532–1545
Pelosi C, Bertrand C, Daniele G, Coeurdassier M, Benoit P, Nélieu S, Lafay F, Bretagnolle V, Gaba S, Vulliet E, Fritsch C (2021) Residues of currently used pesticides in soils and earthworms: a silent threat? Agric Ecosyst Environ. https://doi.org/10.1016/j.agee.2020.107167
Riedo J, Wettstein FE, Rosch A, Herzog C, Banerjee S, Buchi L, Charles R, Wachter D, Martin-Laurent F, Bucheli TD, Walder F, Van Der Heijden MGA (2021) Widespread occurrence of pesticides in organically managed agricultural soils—the ghost of a conventional agricultural past? Environ Sci Technol 55:2919–2928. https://doi.org/10.1021/ACS.EST.0C06405/ASSET/IMAGES/LARGE/ES0C06405_0004.JPEG
Riedo J, Herzog C, Banerjee S, Fenner K, Walder F, Van Der Heijden MGA, Bucheli TD (2022) Concerted evaluation of pesticides in soils of extensive grassland sites and organic and conventional vegetable fields facilitates the identification of major input processes. Environ Sci Technol. https://doi.org/10.1021/acs.est.2c02413
Bernabò I, Guardia A, MacIrella R, Tripepi S, Brunelli E (2017) Chronic exposures to fungicide pyrimethanil: multi-organ effects on Italian tree frog (Hyla intermedia). Sci Rep 7:1–16. https://doi.org/10.1038/s41598-017-07367-6
Bernauer OM, Gaines-Day HR, Steffan SA (2015) Colonies of bumble bees (Bombus impatiens) produce fewer workers, less bee biomass, and have smaller mother queens following fungicide exposure. Insects 6:478–488. https://doi.org/10.3390/insects6020478
Rondeau S, Raine NE (2022) Fungicides and bees: a review of exposure and risk. Environ Int 165:107311. https://doi.org/10.1016/j.envint.2022.107311
Rohr JR, Brown J, Battaglin WA, McMahon TA, Relyea RA (2017) A pesticide paradox: fungicides indirectly increase fungal infections. Ecol Appl 27:2290–2302. https://doi.org/10.1002/eap.1607
Giménez-Moolhuyzen M, van der Blom J, Lorenzo-Mínguez P, Cabello T, Crisol-Martínez E (2020) Photosynthesis inhibiting effects of pesticides on sweet pepper leaves. Insects 11:1–7. https://doi.org/10.3390/insects11020069
Pathak VM, Verma VK, Rawat BS, Kaur B, Babu N, Sharma A, Dewali S, Yadav M, Kumari R, Singh S, Mohapatra A, Pandey V, Rana N, Cunill JM (2022) Current status of pesticide effects on environment, human health and it’s eco-friendly management as bioremediation: a comprehensive review. Front Microbiol 13:1–29. https://doi.org/10.3389/fmicb.2022.962619
Leifheit EF, Camenzind T, Lehmann A, Andrade-Linares DR, Fussan M, Westhusen S, Wineberger TM, Rillig MC (2022) Fungal traits help to understand the decomposition of simple and complex plant litter. bioRxiv. https://doi.org/10.1101/2022.12.06.519268
Lehmann A, Zheng W, Rillig MC (2017) Soil biota contributions to soil aggregation. Nat Ecol Evol 1:1828–1835. https://doi.org/10.1038/s41559-017-0344-y
Lehmann A, Rillig MC (2015) Understanding mechanisms of soil biota involvement in soil aggregation: a way forward with saprobic fungi? Soil Biol Biochem 88:298–302. https://doi.org/10.1016/j.soilbio.2015.06.006
Bhale UN, Bansode SA, Singh S (2018) Multifactorial role of arbuscular mycorrhizae in agroecosystem. Fungi their role. Sustain Dev Curr Perspect. https://doi.org/10.1007/978-981-13-0393-7_12
Begum N, Qin C, Abass Ahanger M, Raza S, Ishfaq Khan M, Ashraf M, Ahmed N, Zhang L, Jammu A, Zhu X (2019) Role of arbuscular mycorrhizal fungi in plant growth regulation: implications in abiotic stress tolerance. Front Plant Sci. https://doi.org/10.3389/fpls.2019.01068
Kang F, Yang B, Wujisiguleng YX, Wang L, Guo J, Sun W, Zhang Q, Zhang T (2020) Arbuscular mycorrhizal fungi alleviate the negative effect of nitrogen deposition on ecosystem functions in meadow grassland. Land Degrad Dev 31:748–759. https://doi.org/10.1002/LDR.3491
Van Der Heijden MGA, Bardgett RD, Van Straalen NM (2008) The unseen majority: soil microbes as drivers of plant diversity and productivity in terrestrial ecosystems. Ecol Lett 11:296–310
(2021) FRAC Code List FRAC Code List ©* 2021: Fungal control agents sorted by cross resistance pattern and mode of action (including coding for FRAC Groups on product labels)
FRAC (2010) FRAC recommendations for fungicide mixtures designed to delay resistance evolution. Fungic Resist Act Comm 1–7
Gisi U (1996) Synergistic interaction of fungicides in mixtures. Phytopathology 86:1273–1279
Abbod M, Mohammad A (2024) Combined interaction of fungicides binary mixtures: experimental study and machine learning-driven QSAR modeling. Sci Rep 14:12700. https://doi.org/10.1038/s41598-024-63708-2
Hobbelen PHF, Paveley ND, Oliver RP, Van Den Bosch F (2013) The usefulness of fungicide mixtures and alternation for delaying the selection for resistance in populations of Mycosphaerella graminicola on winter wheat: a modeling analysis. Phytopathology 103:690–707. https://doi.org/10.1094/PHYTO-06-12-0142-R
Elderfield JAD, Lopez-Ruiz FJ, Van Den Bosch F, Cunniffe NJ (2018) Using epidemiological principles to explain fungicide resistance management tactics: why do mixtures outperform alternations? Phytopathology 108:803–817. https://doi.org/10.1094/PHYTO-08-17-0277-R
Van Den Bosch F, Paveley N, Van Den Berg F, Hobbelen P, Oliver R (2014) Mixtures as a fungicide resistance management tactic. Phytopathology 104:1264–1273. https://doi.org/10.1094/PHYTO-04-14-0121-RVW
Edlinger A, Garland G, Hartman K, Banerjee S, Degrune F, García-Palacios P, Hallin S, Valzano-Held A, Herzog C, Jansa J, Kost E, Maestre FT, Pescador DS, Philippot L, Rillig MC, Romdhane S, Saghaï A, Spor A, Frossard E, van der Heijden MGA (2022) Agricultural management and pesticide use reduce the functioning of beneficial plant symbionts. Nat Ecol Evol 68(6):1145–1154. https://doi.org/10.1038/s41559-022-01799-8
Han L, Xu M, Kong X, Liu X, Wang Q, Chen G, Xu K, Nie J (2022) Deciphering the diversity, composition, function, and network complexity of the soil microbial community after repeated exposure to a fungicide boscalid. Environ Pollut 312:120060. https://doi.org/10.1016/J.ENVPOL.2022.120060
dela Cruz JA, Camenzind T, Rillig MC (2022) Sub-lethal fungicide concentrations both reduce and stimulate the growth rate of non-target soil fungi from a natural grassland. Front Environ Sci 10:1–12. https://doi.org/10.3389/fenvs.2022.1020465
Lehmann A, Zheng W, Ryo M, Soutschek K, Roy J, Rongstock R, Maaß S, Rillig MC (2020) Fungal traits important for soil aggregation. Front Microbiol 10:2904. https://doi.org/10.3389/fmicb.2019.02904
Clements WH, Rohr JR (2009) Community responses to contaminants: using basic ecological principles to predict ecotoxicological effects. Environ Toxicol Chem 28:1789–1800
Andrade-Linares DR, Veresoglou SD, Rillig MC (2016) Temperature priming and memory in soil filamentous fungi. Fungal Ecol 21:10–15. https://doi.org/10.1016/j.funeco.2016.02.002
Camenzind T, Weimershaus P, Lehmann A, Aguilar-Trigueros C, Rillig MC (2022) Soil fungi invest into asexual sporulation under resource scarcity, but trait spaces of individual isolates are unique. Environ Microbiol. https://doi.org/10.1111/1462-2920.16012
Camenzind T, Aguilar-Trigueros CA, Hempel S, Lehmann A, Bielcik M, Andrade-Linares DR, Bergmann J, dela Cruz J, Gawronski J, Golubeva P, Haslwimmer H, Lartey L, Leifheit E, Maaß S, Marhan S, Pinek L, Powell JR, Roy J, Veresoglou SD, Wang D, Wulf A, Zheng W, Rillig MC (2024) Towards establishing a fungal economics spectrum in soil saprobic fungi. Nat Commun 15:3321. https://doi.org/10.1038/s41467-024-47705-7
Zheng W, Lehmann A, Ryo M, Vályi KK, Rillig MC (2020) Growth rate trades off with enzymatic investment in soil filamentous fungi. Sci Rep 10:8–13. https://doi.org/10.1038/s41598-020-68099-8
Leifheit EF, Verbruggen E, Rillig MC (2015) Arbuscular mycorrhizal fungi reduce decomposition of woody plant litter while increasing soil aggregation. Soil Biol Biochem 81:323–328. https://doi.org/10.1016/j.soilbio.2014.12.003
Reischke S, Rousk J, Bååth E (2014) The effects of glucose loading rates on bacterial and fungal growth insoil. Soil Biol Biochem 70:88–95. https://doi.org/10.1016/j.soilbio.2013.12.011
Abiven S, Menasseri S, Chenu C (2009) The effects of organic inputs over time on soil aggregate stability—a literature analysis. Soil Biol Biochem SBB 41:1–12. https://doi.org/10.1016/j.soilbio.2008.09.015
Liang Y, Lehmann A, Ballhausen M-B, Muller L, Rillig MC (2019) Increasing temperature and microplastic fibers jointly influence soil aggregation by saprobic fungi. Front Microbiol. https://doi.org/10.3389/fmicb.2019.02018
Gaspar ML, Cabello MN, Pollero R, Aon MA (2001) Fluorescein diacetate hydrolysis as a measure of fungal biomass in soil. Curr Microbiol 42:339–344. https://doi.org/10.1007/s002840010226
Green VS, Stott DE, Diack M (2006) Assay for fluorescein diacetate hydrolytic activity: optimization for soil samples. Soil Biol Biochem 38:693–701. https://doi.org/10.1016/j.soilbio.2005.06.020
Adam G, Duncan H (2001) Development of a sensitive and rapid method for the measurement of total microbial activity using fluorescein diacetate (FDA) in a range of soils. Soil Biol Biochem 33:943–951. https://doi.org/10.1016/S0038-0717(00)00244-3
Kemper WD, Rosenau Snake RC (1986) Aggregate stability and size distribution. Methods soil analysis part 4 physical methods 1986:317–328. https://doi.org/10.2136/sssabookser5.1.2ed.c17
Ho J, Tumkaya T, Aryal S, Choi H, Claridge-Chang A (2019) Moving beyond P values: data analysis with estimation graphics. Nat Methods 16:565–566. https://doi.org/10.1038/s41592-019-0470-3
Camargo A (2022) PCAtest: testing the statistical significance of principal component analysis in R. PeerJ 10:e12967. https://doi.org/10.7717/peerj.12967
Wickham H (2016) Elegant graphics for data analysis. In: Wickham H (ed) ggplot2. Springer International Publishing, Cham, pp 189–201. https://doi.org/10.1007/978-3-319-24277-4_9
R Core Team (2022) R: the R project for statistical computing. In: R Core Team. https://www.r-project.org/. Accessed 7 Jun 2024
Anderson JPE, Domsch KH (1978) A physiological method for the quantitative measurement of microbial biomass in soils. Soil Biol Biochem 10:215–221. https://doi.org/10.1016/0038-0717(78)90099-8
Luo Y, Zhou X (2006) Soil respiration and the environment. Academic Press, London
Schnürer, Johan and Rosswall T (1996) Fluorescein diacetate hydrolysis as a measure of microbial activity in soil and litter. 43:47–67. https://doi.org/10.1007/978-1-4757-5112-3_3
(FAO) (2011) Isopyrazam
Ma D, Jiang J, Zhu J, Zhang L, Li B, Mu W, Liu F (2020) Evaluation of sensitivity and resistance risk of Corynespora cassiicola to isopyrazam and mefentrifluconazole. Plant Dis 104:2779–2785. https://doi.org/10.1094/PDIS-02-20-0384-RE
Song Y, Zhang Z, Chen L, He L, Lu H, Ren Y, Mu W, Liu F (2016) Baseline sensitivity of botrytis cinerea to the succinate dehydrogenase inhibitor isopyrazam and efficacy of this fungicide. Plant Dis 100:1314–1320. https://doi.org/10.1094/PDIS-10-15-1220-RE
Wood PN, Fisher BM (2017) The effect of fungicides on spore germination, mycelial growth and lesion development of Phlyctema vagabunda (syn: Neofabraea alba) (bull’s eye rot of apples). N Zeal Plant Prot 70:112–119. https://doi.org/10.30843/nzpp.2017.70.36
FAO (2008) Prothioconazole
Hu C, Zhou M, Wang W, Sun X, Yarden O, Li S (2018) Abnormal ergosterol biosynthesis activates transcriptional responses to antifungal azoles. Front Microbiol 9:1–14. https://doi.org/10.3389/fmicb.2018.00009
Petkar A, Langston DB, Buck JW, Stevenson KL, Ji P (2017) Sensitivity of Fusarium oxysporum f. sp. niveum to prothioconazole and thiophanate-methyl and gene mutation conferring resistance to thiophanate-methyl. Plant Dis 101:366–371. https://doi.org/10.1094/PDIS-09-16-1236-RE
Ramirez ML, Chulze S, Magan N (2004) Impact of environmental factors and fungicides on growth and deoxinivalenol production by Fusarium graminearum isolates from Argentinian wheat. Crop Prot 23:117–125. https://doi.org/10.1016/j.cropro.2003.07.005
Muñoz-Leoz B, Ruiz-Romera E, Antigüedad I, Garbisu C (2011) Tebuconazole application decreases soil microbial biomass and activity. Soil Biol Biochem 43:2176–2183. https://doi.org/10.1016/j.soilbio.2011.07.001
Xiong D, Li Y, Xiong Y, Li X, Xiao Y, Qin Z, Xiao Y (2014) Influence of boscalid on the activities of soil enzymes and soil respiration. Eur J Soil Biol 61:1–5. https://doi.org/10.1016/j.ejsobi.2013.12.006
Sułowicz S, Cycoń M, Piotrowska-Seget Z (2016) Non-target impact of fungicide tetraconazole on microbial communities in soils with different agricultural management. Ecotoxicology 25:1047–1060
Lin HF, Dong B, Hu JY (2017) Residue and intake risk assessment of prothioconazole and its metabolite prothioconazole-desthio in wheat field. Environ Monit Assess 189:1–9. https://doi.org/10.1007/s10661-017-5943-1
Epa U, of Pesticide Programs O (2007) US EPA—pesticides—fact sheet for prothioconazole
Parker JE, Warrilow AGS, Cools HJ, Fraaije BA, Lucas JA, Rigdova K, Griffiths WJ, Kelly DE, Kelly SL (2013) Prothioconazole and prothioconazole-desthio activities against Candida albicans sterol 14-α-demethylase. Appl Environ Microbiol 79:1639–1645
Food E, Authority S (2012) Conclusion on the peer review of the pesticide risk assessment of the active substance isopyrazam. EFSA J 10:1–110. https://doi.org/10.2903/j.efsa.2012.2600
Ballu A, Deredec A, Walker AS, Carpentier F (2021) Are efficient-dose mixtures a solution to reduce fungicide load and delay evolution of resistance? An experimental evolutionary approach. Microorganisms. https://doi.org/10.3390/microorganisms9112324
Wang C, Wang F, Zhang Q, Liang W (2016) Individual and combined effects of tebuconazole and carbendazim on soil microbial activity. Eur J Soil Biol 72:6–13. https://doi.org/10.1016/j.ejsobi.2015.12.005
Wang X, Lu Z, Miller H, Liu J, Hou Z, Liang S, Zhao X, Zhang H, Borch T (2020) Fungicide azoxystrobin induced changes on the soil microbiome. Appl Soil Ecol 145:103343. https://doi.org/10.1016/j.apsoil.2019.08.005
Baćmaga M, Wyszkowska J, Borowik A, Kucharski J (2022) Effects of tebuconazole application on soil microbiota and enzymes. Molecules. https://doi.org/10.3390/molecules27217501
Alberts B, Johnson A, Lewis J, Raff M, Roberts K, Walter P (2002) Molecular biology of the cell. Garland Science, NY, USA
Turner BL, Hopkins DW, Haygarth PM, Ostle N (2002) Β-glucosidase activity in pasture soils. Appl Soil Ecol 20:157–162. https://doi.org/10.1016/S0929-1393(02)00020-3
Baćmaga M, Wyszkowska J, Kucharski J (2020) Response of soil microorganisms and enzymes to the foliar application of Helicur 250 EW fungicide on Horderum vulgare L. Chemosphere 242:125163. https://doi.org/10.1016/j.chemosphere.2019.125163
Riah W, Laval K, Laroche-Ajzenberg E, Mougin C, Latour X, Trinsoutrot-Gattin I (2014) Effects of pesticides on soil enzymes: a review. Environ Chem Lett 12:257–273. https://doi.org/10.1007/s10311-014-0458-2
Richardson AE, Simpson RJ (2011) Soil microorganisms mediating phosphorus availability. Plant Physiol 156:989–996. https://doi.org/10.1104/pp.111.175448
Monkiedje A, Spiteller M (2002) Effects of the phenylamide fungicides, mefenoxam and metalaxyl, on the microbiological properties of a sandy loam and a sandy clay soil. Biol Fertil Soils 356(35):393–398. https://doi.org/10.1007/S00374-002-0485-1
Qian H, Hu B, Wang Z, Xu X, Hong T (2007) Effects of validamycin on some enzymatic activities in soil. Environ Monit Assess 125:1–8. https://doi.org/10.1007/S10661-006-9211-Z
Tejada M, Gómez I, García-Martínez AM, Osta P, Parrado J (2011) Effects of Prochloraz fungicide on soil enzymatic activities and bacterial communities. Ecotoxicol Environ Saf 74:1708–1714. https://doi.org/10.1016/j.ecoenv.2011.04.016
Baćmaga M, Kucharski J, Wyszkowska J (2019) Microbiological and biochemical properties of soil polluted with a mixture of spiroxamine, tebuconazole, and triadimenol under the cultivation of Triticum aestivum L. Environ Monit Assess. https://doi.org/10.1007/s10661-019-7539-4
Filimon MN, Voia SO, Vladoiu DL, Isvoran A, Ostafe V (2015) Temperature dependent effect of difenoconazole on enzymatic activity from soil. J Serb Chem Soc 80:1127–1137. https://doi.org/10.2298/JSC141218030F
Walia A, Mehta P, Guleria S, Chauhan A, Shirkot CK (2014) Impact of fungicide mancozeb at different application rates on soil microbial populations, soil biological processes, and enzyme activities in soil. Sci World J. https://doi.org/10.1155/2014/702909
Piotrowska-Seget Z, Engel R, Nowak E, Kozdrój J (2008) Successive soil treatment with captan or oxytetracycline affects non-target microorganisms. World J Microbiol Biotechnol 24:2843–2848. https://doi.org/10.1007/s11274-008-9815-2
Cycoń M, Piotrowska-Seget Z, Kozdrój J (2010) Responses of indigenous microorganisms to a fungicidal mixture of mancozeb and dimethomorph added to sandy soils. Int Biodeterior Biodegrad 64:316–323. https://doi.org/10.1016/J.IBIOD.2010.03.006
Ekenler M, Tabatabai MA (2004) Β-glucosaminidase activity as an index of nitrogen mineralization in soils. Commun Soil Sci Plant Anal 35:1081–1094. https://doi.org/10.1081/CSS-120030588
Vidhate RP, Bhide AJ, Giri AP (2023) Functional characterization of N-acetyl glucosaminidase from Myrothecium verrucaria for bio-control of plant pathogenic fungi and bio-production of N-acetyl glucosamine. Process Biochem 129:102–112. https://doi.org/10.1016/j.procbio.2023.03.010
Riah-Anglet W, Trinsoutrot-Gattin I, Norini M-P, Gauthier A, Latour X, Laval K (2018) Initial state of soil microbial communities determines their stress response. J Environ Chem Eng 6:5470–5480. https://doi.org/10.1016/j.jece.2018.08.019
Chao CF, Chen YY, Cheng CY, Li YK (2013) Catalytic function of a newly purified exo-β-d-glucosaminidase from the entomopathogenic fungus Paecilomyces lilacinus. Carbohydr Polym 93:615–621. https://doi.org/10.1016/j.carbpol.2012.12.030
Chen X, Xia W, Yu X (2005) Purification and characterization of two types of chitosanase from Aspergillus sp. CJ22-326. Food Res Int 38:315–322. https://doi.org/10.1016/j.foodres.2004.04.012
Nidheesh T, Gaurav Kumar P, Suresh PV (2015) Enzymatic degradation of chitosan and production of d-glucosamine by solid substrate fermentation of exo-β-d-glucosaminidase (exochitosanase) by Penicillium decumbens CFRNT15. Int Biodeterior Biodegrad 97:97–106. https://doi.org/10.1016/j.ibiod.2014.10.016
Yang X, Gong R, Chu Y, Liu S, Xiang D, Li C (2022) Mechanistic insights into stereospecific antifungal activity of chiral fungicide Prothioconazole against Fusarium oxysporum F. sp. cubense. Int J Mol Sci. https://doi.org/10.3390/ijms23042352
Kathiravan MK, Salake AB, Chothe AS, Dudhe PB, Watode RP, Mukta MS, Gadhwe S (2012) The biology and chemistry of antifungal agents: a review. Bioorgan Med Chem 20:5678–5698. https://doi.org/10.1016/j.bmc.2012.04.045
Zheng W, Morris EK, Rillig MC (2014) Ectomycorrhizal fungi in association with Pinus sylvestris seedlings promote soil aggregation and soil water repellency. Soil Biol Biochem 78:326–331. https://doi.org/10.1016/j.soilbio.2014.07.015
Caesar-Tonthat T-C, Cochran VL (2000) Soil aggregate stabilization by a saprophytic lignin-decomposing basidiomycete fungus I. Microbiological aspects. Springer-Verlag, Cham
Baudy P, Zubrod JP, Konschak M, Röder N, Nguyen TH, Schreiner VC, Baschien C, Schulz R, Bundschuh M (2021) Environmentally relevant fungicide levels modify fungal community composition and interactions but not functioning. Environ Pollut. https://doi.org/10.1016/j.envpol.2021.117234
Bending GD, Rodríguez-Cruz MS, Lincoln SD (2007) Fungicide impacts on microbial communities in soils with contrasting management histories. Chemosphere 69:82–88. https://doi.org/10.1016/j.chemosphere.2007.04.042
Jia J, Zhang J, Li Y, Koziol L, Podzikowski L, Delgado-Baquerizo M, Wang G, Zhang J (2023) Relationships between soil biodiversity and multifunctionality in croplands depend on salinity and organic matter. Geoderma 429:116273. https://doi.org/10.1016/j.geoderma.2022.116273
Wu X, Xu J, Dong F, Liu X, Zheng Y (2014) Responses of soil microbial community to different concentration of fomesafen. J Hazard Mater 273:155–164. https://doi.org/10.1016/j.jhazmat.2014.03.041
Acknowledgements
Not applicable.
Funding
Open Access funding enabled and organized by Projekt DEAL. We acknowledge support by the Open Access Publication Initiative of Freie Universität Berlin. JdC acknowledges support from the German Academic Exchange Service (DAAD). BX acknowledges the support from the Rising Star Fellowship of the Freie Universität Berlin.
Author information
Authors and Affiliations
Contributions
JdC conceptualized and designed the study, performed the experiment, analyzed the data, and wrote the first draft of the paper; TC assisted in analyzing the data, reviewed and edited the paper; BX reviewed and edited the paper. MR reviewed and edited the paper. All authors contributed to the revision and approved the final revision of the manuscript.
Corresponding author
Ethics declarations
Ethics approval and consent to participate
Not applicable.
Consent for publication
Not applicable.
Competing interests
The authors declare no competing interests.
Additional information
Publisher's Note
Springer Nature remains neutral with regard to jurisdictional claims in published maps and institutional affiliations.
Supplementary Information
Rights and permissions
Open Access This article is licensed under a Creative Commons Attribution 4.0 International License, which permits use, sharing, adaptation, distribution and reproduction in any medium or format, as long as you give appropriate credit to the original author(s) and the source, provide a link to the Creative Commons licence, and indicate if changes were made. The images or other third party material in this article are included in the article's Creative Commons licence, unless indicated otherwise in a credit line to the material. If material is not included in the article's Creative Commons licence and your intended use is not permitted by statutory regulation or exceeds the permitted use, you will need to obtain permission directly from the copyright holder. To view a copy of this licence, visit http://creativecommons.org/licenses/by/4.0/.
About this article
Cite this article
dela Cruz, J.A., Camenzind, T., Xu, B. et al. Limited role of fungal diversity in maintaining soil processes in grassland soil under concurrent fungicide stress. Environ Sci Eur 36, 156 (2024). https://doi.org/10.1186/s12302-024-00983-w
Received:
Accepted:
Published:
DOI: https://doi.org/10.1186/s12302-024-00983-w